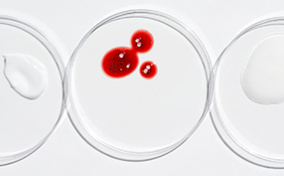
A petri dish with drops of period blood sits between two other petri dishes with skin care products.

The Authority on Sexual Health. We want to help readers take control of their sexual health with illuminating content that will enhance their quality of life.
- Get in Touch With Us
- Terms & Conditions
- Privacy Policy
- Cookie Policy
Customer Service
By continuing use of this site, you agree to the Terms of Use and Privacy Policy.
DISCLAIMER: THIS WEBSITE DOES NOT PROVIDE MEDICAL ADVICE
The information, including but not limited to, text, graphics, images and other material contained on this Website are for informational purposes only. No material on this website is intended to be a substitute for professional medical advice, diagnosis or treatment. Always seek the advice of your physician or other qualified healthcare provider with any questions you may have regarding a medical condition or treatment and before undertaking a new healthcare regimen, and never disregard professional medical advice or delay in seeking it because of something you have read on this Website. See additional information.
By continuing use of this site, you agree to the Terms of Use and Privacy Policy.
DISCLAIMER: THIS WEBSITE DOES NOT PROVIDE MEDICAL ADVICE
The information, including but not limited to, text, graphics, images and other material contained on this Website are for informational purposes only. No material on this website is intended to be a substitute for professional medical advice, diagnosis or treatment. Always seek the advice of your physician or other qualified healthcare provider with any questions you may have regarding a medical condition or treatment and before undertaking a new healthcare regimen, and never disregard professional medical advice or delay in seeking it because of something you have read on this Website. See additional information.
Our Brands:
By continuing use of this site, you agree to the Terms of Use and Privacy Policy.
DISCLAIMER: THIS WEBSITE DOES NOT PROVIDE MEDICAL ADVICE
The information, including but not limited to, text, graphics, images and other material contained on this Website are for informational purposes only. No material on this website is intended to be a substitute for professional medical advice, diagnosis or treatment. Always seek the advice of your physician or other qualified healthcare provider with any questions you may have regarding a medical condition or treatment and before undertaking a new healthcare regimen, and never disregard professional medical advice or delay in seeking it because of something you have read on this Website. See additional information.
© Copyright 2025 Giddy® | All Rights Reserved.
© Copyright 2025 Giddy® | All Rights Reserved.
Tag search
Type in the topics you’re interested in. Use multiple tags to find articles more related to what you’re looking for.
What Do You Know About Postmenstrual Syndrome?
Symptoms of your period can linger and cause anxiety after it is finished.
Can You Benefit from a Little Healthy Nudity?
Explore the benefits of nudism: Stripping down to boost your sexual well-being.
By Ally Sweeten
The Period Skincare Routine You've Been Looking For
Struggling with hormonal acne or dry skin? Try syncing your products with your menstrual cycle.
By Coralle Skye
How to Fight Borderline Low Testosterone Without Medication
Your androgen levels are not drastically low, but they're not super-high, either. So now what?
By David Hopper
A Beginner's Guide to Aromatherapy for Sexual Health
Emerging science points to more and more positive effects of essential oils.
By Kate Daniel